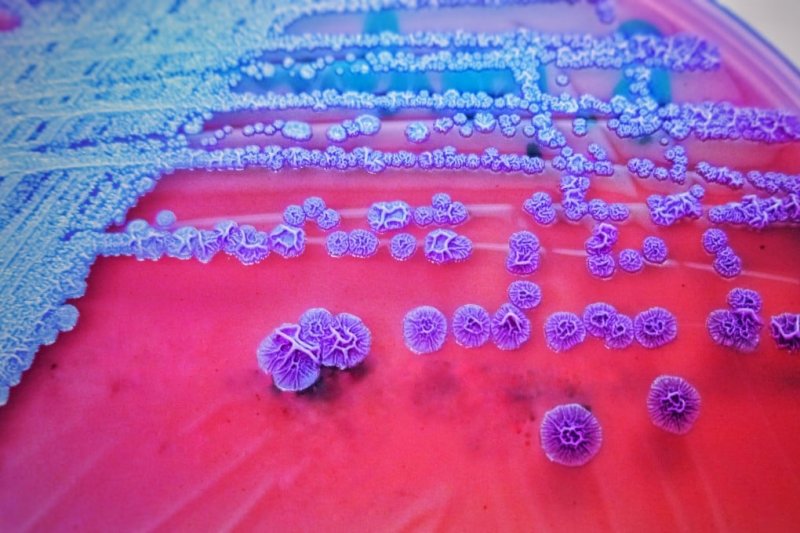
Melioidosis outbreak in northeast Australia claims 26 lives

Melioidosis outbreak in northeast Australia claims 26 lives
The death toll from a tropical disease outbreak in Australia's northeast has risen to 26.
According to new data from the Department of Health in the state of Queensland, there have been 10 new cases of melioidosis, including one fatality, reported in the state in the last seven days, News.Az reports, citing foreign media.
It takes the total number of deaths from the soil-borne disease in Queensland to 26 amid an outbreak linked to heavy rainfall and severe flooding that hit the state's tropical northeast coast region in January and February.
Melioidosis is a rare tropical disease caused by bacteria commonly found in soil and water in Southeast Asia and northern Australia. After heavy rainfall it becomes airborne.
Townsville, the largest city affected by the historic flooding in January and February, has already recorded its wettest year on record. As of April 5, the city had received 2,419.8 millimeters of rainfall since Jan. 1, surpassing the previous record of 2,400 millimeters set in the year 2000.
Queensland Health has urged people in areas affected by the outbreak to avoid contact with soil or muddy water, to wear footwear and gloves for gardening or while working outdoors and to consider using a mask when using a high-pressure hose around soil.



























